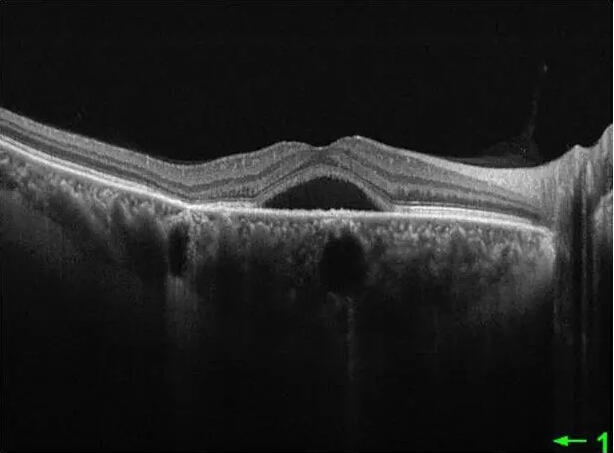

本文转自: 张新媛 张新媛
大夫眼中的眼底病视界
中心性浆液性视网膜脉络膜病变
(CSC)是一种由于脉络膜病变
以及视网膜色素上皮(RPE)屏
障功能受损引起液体进入神经上
皮下导致神经上皮脱离的疾病,
也可伴有 RPE 脱离,简称“中浆”
,是常见的眼底疾病。

患者突然出现不同程度视力下降、
视物变形、视物变色变暗、出现
中心或旁中心暗点,多见于青年
及青壮年,40岁左右为发病高峰。
男女发病比例约为6:1。患眼最佳
矫正视力可在0.1-1.0之间。大多
数患者为单眼发病(90%),左
右眼发病无差别。
病因有哪些?
中浆发病的确切病因还不清楚,
但公认脉络膜毛细血管渗漏与视
网膜外屏障功能失调是发病的根
本原因,原发病灶在视网膜色素
上皮和脉络膜毛细血管。RPE功
能失调理论/弥散理论和脉络膜
功能失调/脉络膜高渗漏理论相
继提出。
临床表现有哪些?
急性CSC:疾病常具有自限性,
对患者视力影响较小。但病程超
过6个月的的慢性CSC会因并发症
(如外部视网膜萎缩,新血管形
成,囊性黄斑变性和大疱性视网
膜脱离。)而影响视力。OCT常
表现为浆液性神经上皮或色素上
皮脱离呈典型的平滑凸起、脉络
膜增厚。
一例45岁“中浆”的男性患者:O
CT显示黄斑区神经上皮脱离及
脉络膜厚度增加。
慢性CSC:发病特征为发生视网
膜下液且伴RPE改变。OCT还可
以显示外层的视网膜病变,如与
慢性视网膜下液相关的增厚的感
光器外节段和椭圆带以及外界膜
断裂。CSC并发1型脉络膜新生血
管的眼,36%会进展到特发性息
肉样脉络膜血管病变。
诊断与鉴别诊断
详细的眼底检查,眼底荧光血管
造影(可发现渗漏点)及脉络膜
造影(脉络膜高灌注)以及OCT
检查可对中浆进行确诊。另外诊
断时还需要与下方周边部视网膜
脱离(累及黄斑部)、中间部葡
萄膜炎、中心性渗出性脉络膜病
变以及先天性视盘小凹进行鉴别。
如何治疗?
根据荧光造影所确定的渗漏点的
位置、病史、神经上皮脱离的范
围以及脉络膜造影所发现的脉络
膜高灌注的情况,医生会选择1)
光动力疗法 2)激光光凝 3)药
物等治疗。
如何预防?
有的患者会出现复发倾向。由于
发病的诱因可能与A型性格、免
疫、精神紧张、饮酒、睡眠不佳、
过劳、病源及全身性感染、过敏、
外界寒冷等因素有关。因此应避
免诱发本病的诸多因素,以避免
疾病复发以及对侧眼发病。
更多新闻请点击 :


